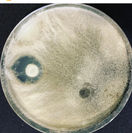

La vida empieza
por lo más pequeño


Bioinsumos y microbiología agrícola
Bienvenidos a nuestro laboratorio, donde nos especializamos en la producción y venta de bioinsumos microbianos de calidad. Ofrecemos servicios microbiológicos aplicados que contribuyen al desarrollo sostenible y a la salud del suelo. Nuestro compromiso es proporcionar soluciones innovadoras queicien tanto a la agricultura como al medio ambiente. Desc cómo nuestros productos pueden transformar tu cultivo y mejorar tus resultados.
En Laboratorio Microbiolab trabajamos con microorganismos agrícolas seleccionados, producidos y manejados bajo criterios técnicos, con el objetivo de apoyar la sanidad del suelo, la nutrición vegetal y el manejo biológico de plagas y enfermedades.
Nuestros productos no están pensados como soluciones genéricas, sino como herramientas biológicas que deben utilizarse de acuerdo con el cultivo, el sistema de manejo y el objetivo agronómico.
#donde #comprar #trichoderma #bioinsumos #ecuador #venta #bioinsumos #bacillus #microbiolab #ecuador #entomopatogenos #beauveria #lecanicillium
Presentación Líquida
La presentación líquida consiste en microorganismos en suspensión, con células viables metabólicamente activas al momento de la entrega. Este tipo de formulación está pensada para facilitar la aplicación y asegurar una respuesta biológica más rápida en el suelo o en la zona radicular.
Al encontrarse activos, los microorganismos en presentación líquida no requieren procesos de activación previa. Únicamente se recomienda agitar el envase y realizar la dilución correspondiente en agua limpia antes de su aplicación. Esto reduce errores de manejo y permite una incorporación más uniforme en el sistema productivo.
Su uso es especialmente adecuado para:
-
Aplicaciones vía riego, drench o riego localizado
-
Superficies medianas y grandes
-
Sistemas con riego tecnificado
-
Situaciones donde se busca una acción biológica inmediata
Desde el punto de vista técnico, la ventaja principal de la presentación líquida es que los microorganismos comienzan a interactuar con el suelo y la raíz de forma casi inmediata, favoreciendo procesos como colonización radicular, competencia con patógenos y estimulación biológica temprana.
Esta presentación es ideal cuando se requiere practicidad, rapidez y uniformidad, siempre considerando que, al tratarse de organismos vivos activos, debe manejarse adecuadamente en cuanto a almacenamiento, tiempos de uso y compatibilidad con otros insumos.
Presentación Sólida
La presentación sólida consiste en microorganismos en forma de esporas deshidratadas, adheridas a un sustrato portador. En este estado, los microorganismos se encuentran viables pero metabólicamente inactivos, lo que les confiere una mayor estabilidad durante el almacenamiento.
Esta presentación está diseñada para una liberación lenta y progresiva del microorganismo una vez que entra en contacto con la humedad del suelo. Al hidratarse, las esporas se activan y comienzan su proceso de colonización, por lo que su efecto no es inmediato, sino gradual.
El uso de la presentación sólida es especialmente recomendable para:
-
Preparación biológica del suelo antes de la siembra
-
Aplicación directa en hoyos de plantación
-
Viveros y áreas pequeñas
-
Manejos donde se busca establecer microbiología de forma sostenida
Desde el punto de vista técnico, esta presentación permite anticiparse al cultivo, creando un ambiente biológico favorable antes de que la raíz se desarrolle. Por esta razón, es común utilizarla en etapas previas al establecimiento del cultivo o en sistemas donde no se dispone de riego constante.
La presentación sólida requiere hidratación para que el microorganismo se active, ya sea directamente en el suelo o mediante un proceso previo de rehidratación controlada. Su correcta aplicación depende del momento, la humedad disponible y el objetivo del manejo biológico, más que de la dosis por sí sola.
Presentacion en Gel
La presentación en gel corresponde a microorganismos metabólicamente activos, incorporados en una matriz semisólida que les brinda mayor protección y estabilidad frente a condiciones ambientales adversas. Esta formulación está diseñada para reducir el estrés del microorganismo, mejorar su supervivencia y favorecer una liberación gradualuna vez aplicado en el suelo.
A diferencia de la presentación líquida, el gel permite que los microorganismos permanezcan más tiempo en la zona de aplicación, evitando pérdidas rápidas por escorrentía, lixiviación o evaporación. Por esta razón, resulta especialmente útil en aplicaciones localizadas, donde se busca una interacción directa con la raíz o el sustrato inmediato.
La presentación en gel se recomienda principalmente para:
-
Trasplantes
-
Aplicaciones directas en la zona radicular
-
Viveros y macetas
-
Suelos con baja retención de humedad
Desde el punto de vista técnico, el gel actúa como un vehículo protector, facilitando que el microorganismo se establezca de forma más eficiente en la rizósfera. Al igual que la presentación líquida, no requiere activación previa, únicamente una dilución controlada cuando se va a aplicar.
Esta presentación es especialmente adecuada cuando se busca equilibrar estabilidad y actividad biológica, ofreciendo una alternativa intermedia entre la rapidez del líquido y la estabilidad del sólido. Su correcta utilización contribuye a un mejor establecimiento microbiano y a una respuesta biológica más consistente en el tiempo.
Microorganismos
Hongos Benéficos
-
Trichoderma spp.
Antagonista de patógenos del suelo, promotor de crecimiento radicular y sanidad del sistema radicular. -
Beauveria bassiana
Hongo entomopatógeno para control biológico de insectos. -
Lecanicillium lecanii
Control biológico de insectos de cuerpo blando como mosca blanca, trips y pulgones. -
Paecilomyces lilacinus
Manejo biológico de nematodos. -
Gliocladium roseum
Antagonista de hongos fitopatógenos del suelo. -
Arthrobotrys oligospora
Hongo atrapador de nematodos. -
Penicillium janthinellum
Hongo del suelo con alta capacidad enzimática y solubilizadora. Participa en la solubilización de fósforo, producción de ácidos orgánicos y mejora de la disponibilidad de nutrientes para la planta.
Bacterias benéficas
-
Bacillus thuringiensis
Control biológico de insectos lepidópteros. -
Bacillus licheniformis
Producción de enzimas y apoyo a la nutrición vegetal. -
Bacillus polymyxa
Bacteria rizosférica promotora de crecimiento vegetal. Fijadora de nitrógeno no simbiótica, productora de fitohormonas y metabolitos con efecto antagonista frente a patógenos del suelo. -
Bacillus spp.
Promoción de crecimiento vegetal y control biológico. -
Pseudomonas spp.
Solubilización de nutrientes y control de patógenos del suelo. -
Rhizobium spp.
Fijación biológica de nitrógeno en leguminosas. -
Lactobacillus spp.
Regulación microbiana y apoyo en procesos biológicos.
Levaduras
-
Saccharomyces cerevisiae
Estimulación biológica y soporte en procesos de fermentación.


Nuestra Historia
Bienvenido a Microbiolab Bioinsumos Ecuatorianos
Microbiolab es un laboratorio especializado en microbiología aplicada, enfocado en los sectores agrícola, pecuario y ambiental. Nuestra misión es ofrecer soluciones innovadoras y de alta calidad para mejorar la productividad y sostenibilidad en estos importantes sectores.
Fundado en 2015, nuestro laboratorio está ubicado en la ciudad de Quito, Ecuador. Contamos con un equipo de expertos altamente calificados y equipamiento de última generación para garantizar resultados precisos y confiables.
En Microbiolab, nos dedicamos a brindar servicios especializados como análisis de suelos, aguas, alimentos y productos agrícolas (bioinsumos microbianos), y la identificación de patógenos en animales, entre otros. Nuestro compromiso con la excelencia nos ha posicionado como líderes en el mercado y nos ha permitido establecer relaciones sólidas con nuestros clientes.
Estamos comprometidos con la investigación científica y la innovación constante para estar a la vanguardia de las últimas tecnologías y tendencias en microbiología aplicada. Además, somos fabricantes de bioinsumos con una amplia variedad de cepas en Ecuador, ofreciendo productos de la más alta calidad para diversas aplicaciones agrícolas.
Confíe en Microbiolab para obtener resultados precisos y confiables que impulsen el éxito de su negocio en los sectores agrícola, pecuario y ambiental.
¡Contáctenos hoy mismo para conocer más sobre nuestros servicios!
#bioinsumos #ecuador #bioinsumosecuatorianos
Responsable Técnico
Mi nombre es Esther Cortez
Mis estudios de pregrado los realicé en la Pontificia Universidad Católica del Ecuador en la profesión de microbiología clínica y aplicada, posteriormente dediqué mi vida profesional a la microbiología agrícola, de aguas y alimentos. En el ámbito laboral realicé e implementé los procesos de control de calidad, validación y su respectiva acreditación en diferentes técnicas microbiológicas de aguas y alimentos en varios laboratorios de alimentos y ambientales de la ciudad de Quito. En el sector agrícola trabajé en diferentes instituciones realizando análisis de fitopatología, microbiología agrícola e investigación y desarrollo de microorganismos de uso agrícola. Mis estudios de posgrado los realicé en la Universidad Agraria del Ecuador en el programa de Magister en Agroecología y Agricultura Sostenibles, especializándome así en el manejo agroecológico de los cultivos completando de esta manera mi formación académica en el área agrícola para poder brindarles un asesoramiento integrado del manejo de los cultivos con las bases de la microbiología agrícola.


Portafolio fotográfico
Cada fotografía cuenta una historia, y me siento feliz de estar en el momento adecuado para capturar los recuerdos especiales de nuestro trabajo. Como fotógrafa dedicada y apasionada, me fascina capturar con la cámara momentos únicos. Desde que comencé mi carrera profesional como Microbióloga, he trabajado en muchos tipos diferentes de proyectos que han ampliado mi experiencia y mi cartera. Te invito a explorar mi trabajo y, si tienes alguna pregunta, no dudes en contactarme.
Esther Cortez
By @estercortezp
Address
Urbanización Santa Mónica
El Quinche
Ecuador
Phone
+593 995612043
+593 963108684